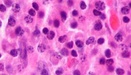

Данные успешо отправлены .
Мы свяжемся с Вами в ближайшее время.
Новости
Отделения больницы


лучшим !



Монопольный бизнес позволяет устанавливать любые цены на лекарства.
Ученые изучили, как развиваются злокачественные опухоли ALK+ и ROS1+.
Новый метод точнее работает, чем стандарные мазки Папаниколау.
Исследователи обнаружили, что кровоток необходим для процесса экстравазации, когда опухолевые клетки покидают кровеносный сосуд и пересекают эндотелиальный барьер на новом участке.
Ученые надеются, что результаты их работы помогут в разработке новых методов лечения миеломы.
Ученые изучили влияние препаратов на протеом плазмы человека.
Ученые нашли механизм при котором развивается лейкемия у детей.
Для связи с медицинским консультантом заполните форму:
Отправляя форму Вы соглашаетесь с политикой конфиденциальности